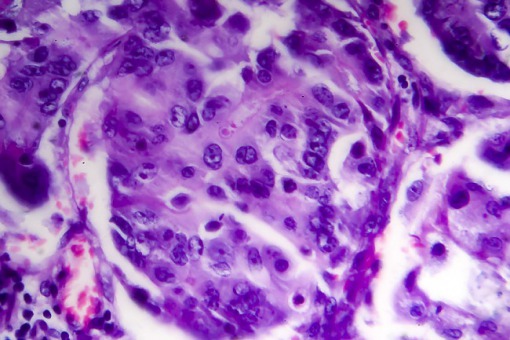

Przerzutowy rak jelita grubego - opis przypadku
59-letni mężczyzna z przerzutowym rakiem jelita grubego miał różowe, jędrne zmiany skórne wokół blizny chirurgicznej brzucha. Biopsja potwierdziła przerzuty skórne.
Na łamach The New England Journal of Medicine opublikowano przypadek, 59-letniego mężczyzny z przerzutowym rakiem okrężnicy skierowanego do kliniki dermatologicznej z podejrzeniem półpaśca. U pacjenta od 10 tygodni obserwowano zmiany skórne zlokalizowane wokół dużej blizna brzucha po hemikolektomii wykonanej 3 lata wcześniej. Przez to nacięcie wykonano również resekcję wątroby i cholecystektomię. Podczas badania zmiany skórne były jędrne, różowawe do fiołkowatych pojawiały się również pęcherzykowe; u pacjenta zaobserwowano wodobrzusze. Po przeprowadzaniu biopsji skóry potwierdzono diagnozę gruczolakoraka przerzutowego. Najczęstsze miejsce przerzutu w przypadku gruczolakoraka jelita grubego to skóra brzucha, czasami w okolicach blizny chirurgiczne, jak widać w tym przypadku. Pacjent zmarł 5 miesięcy po prezentacji.



